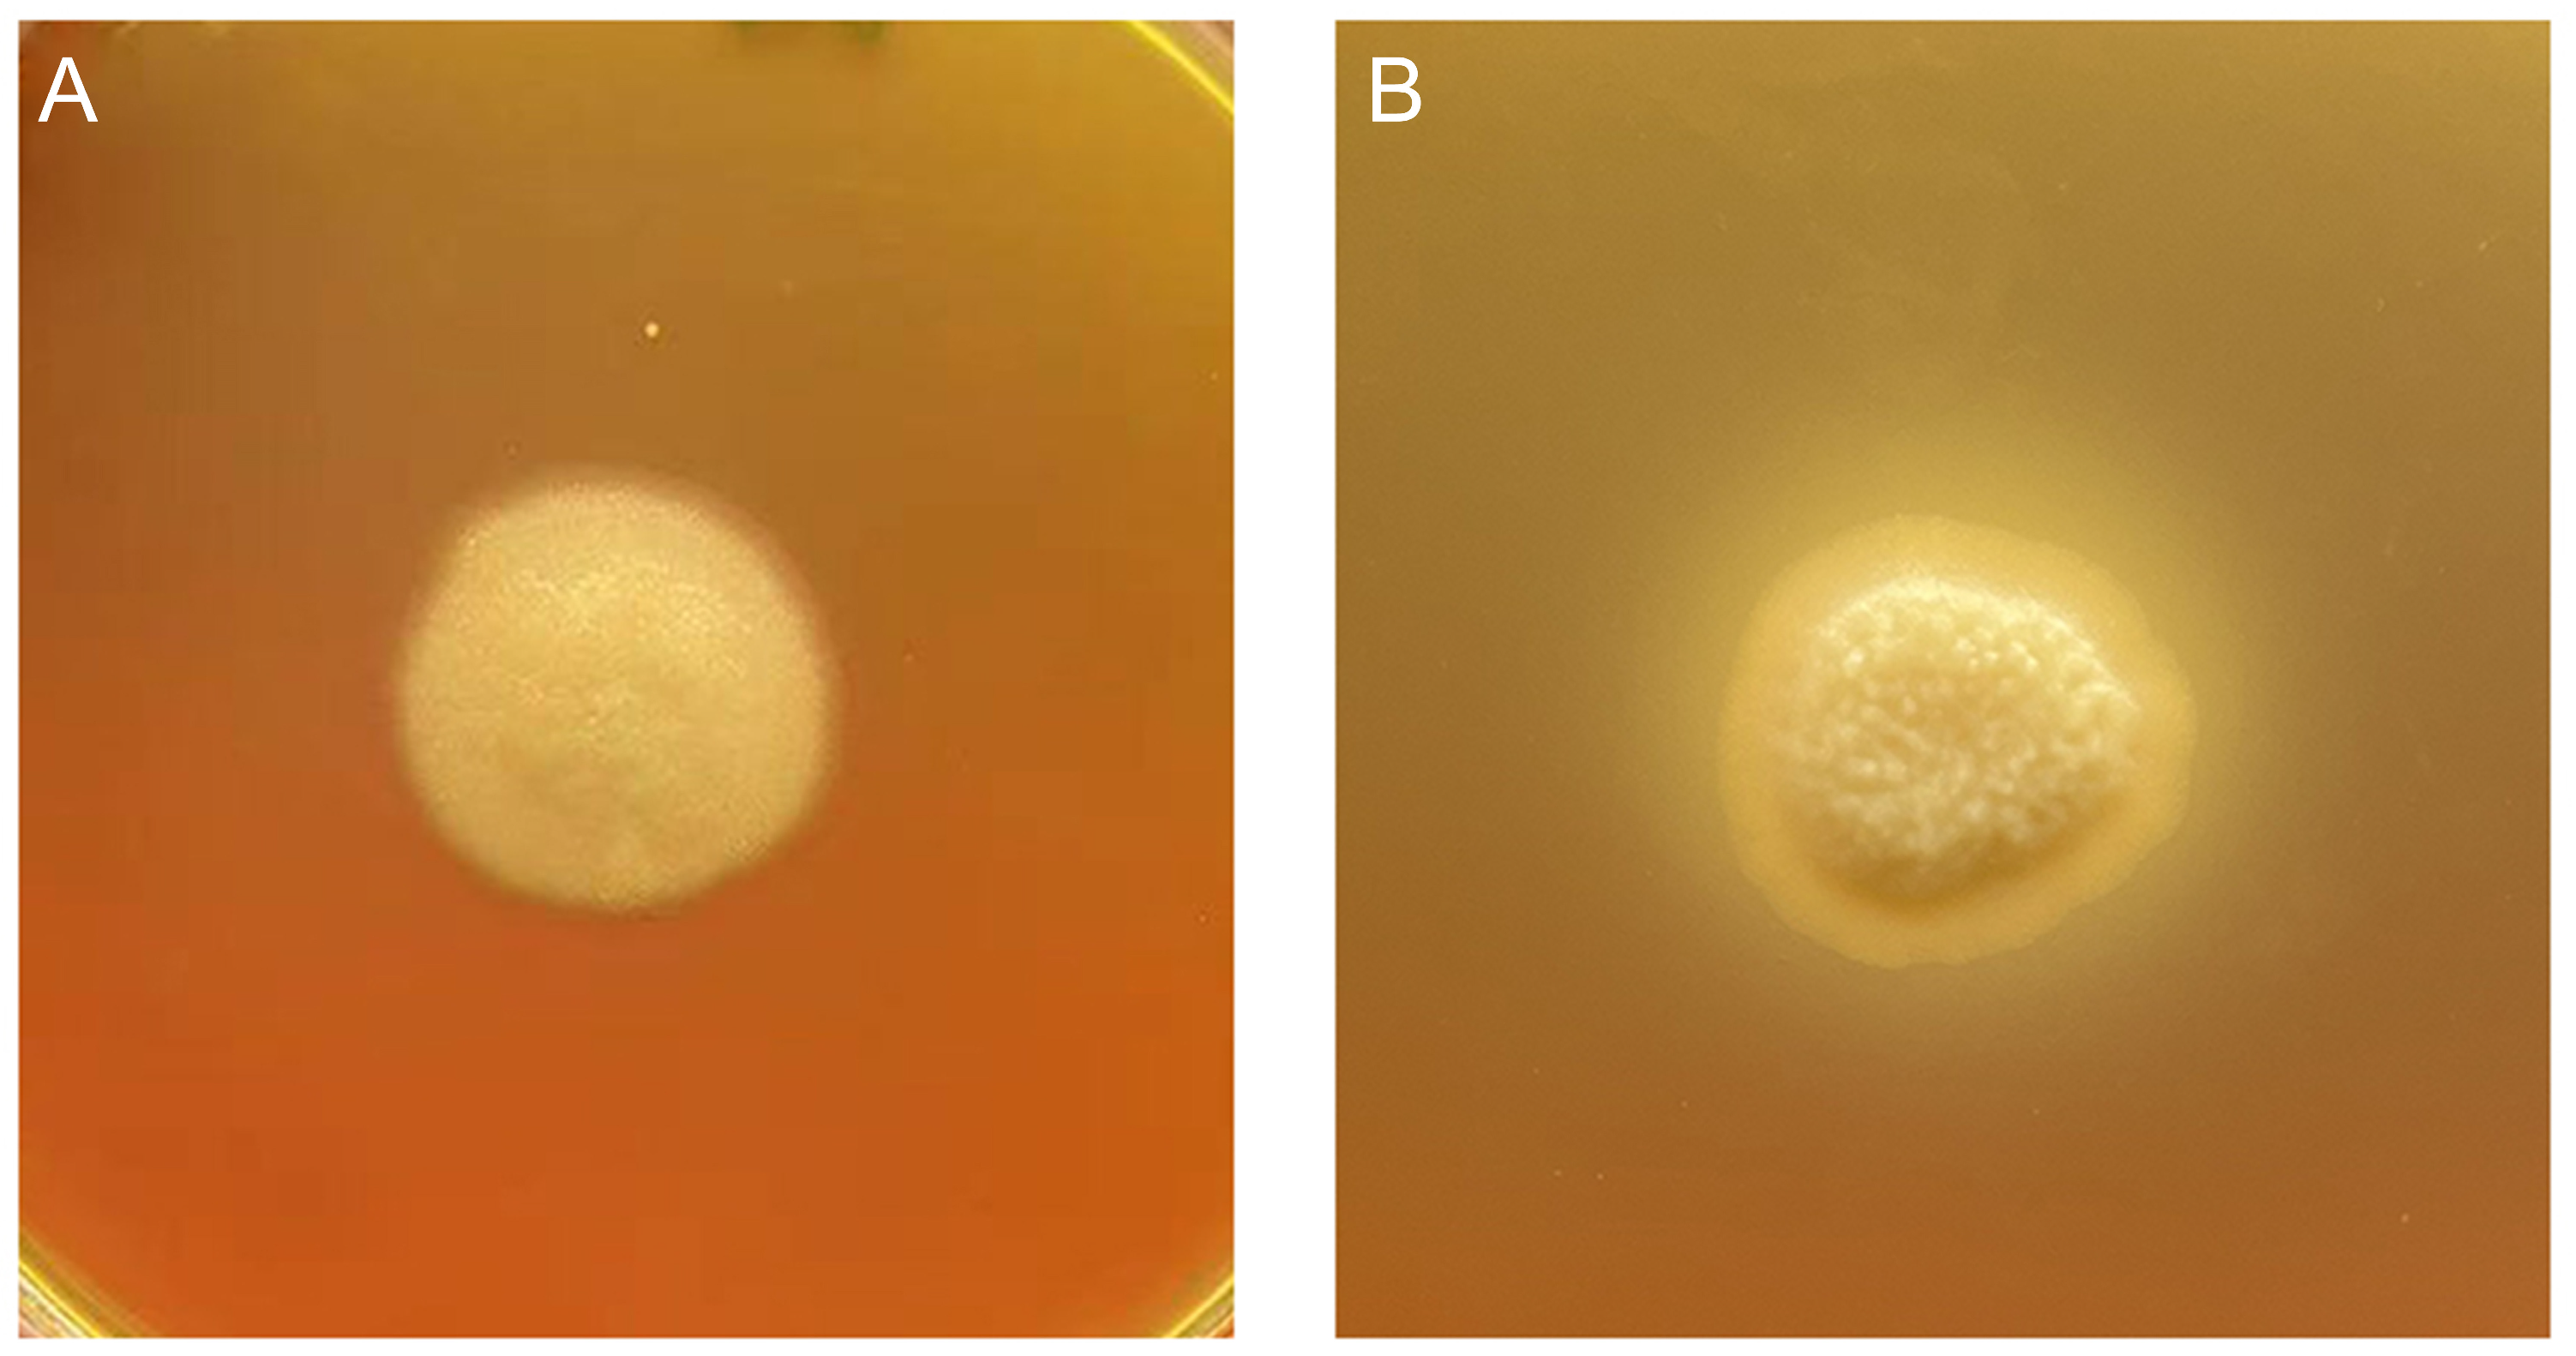
Ijms 24 08855 g003
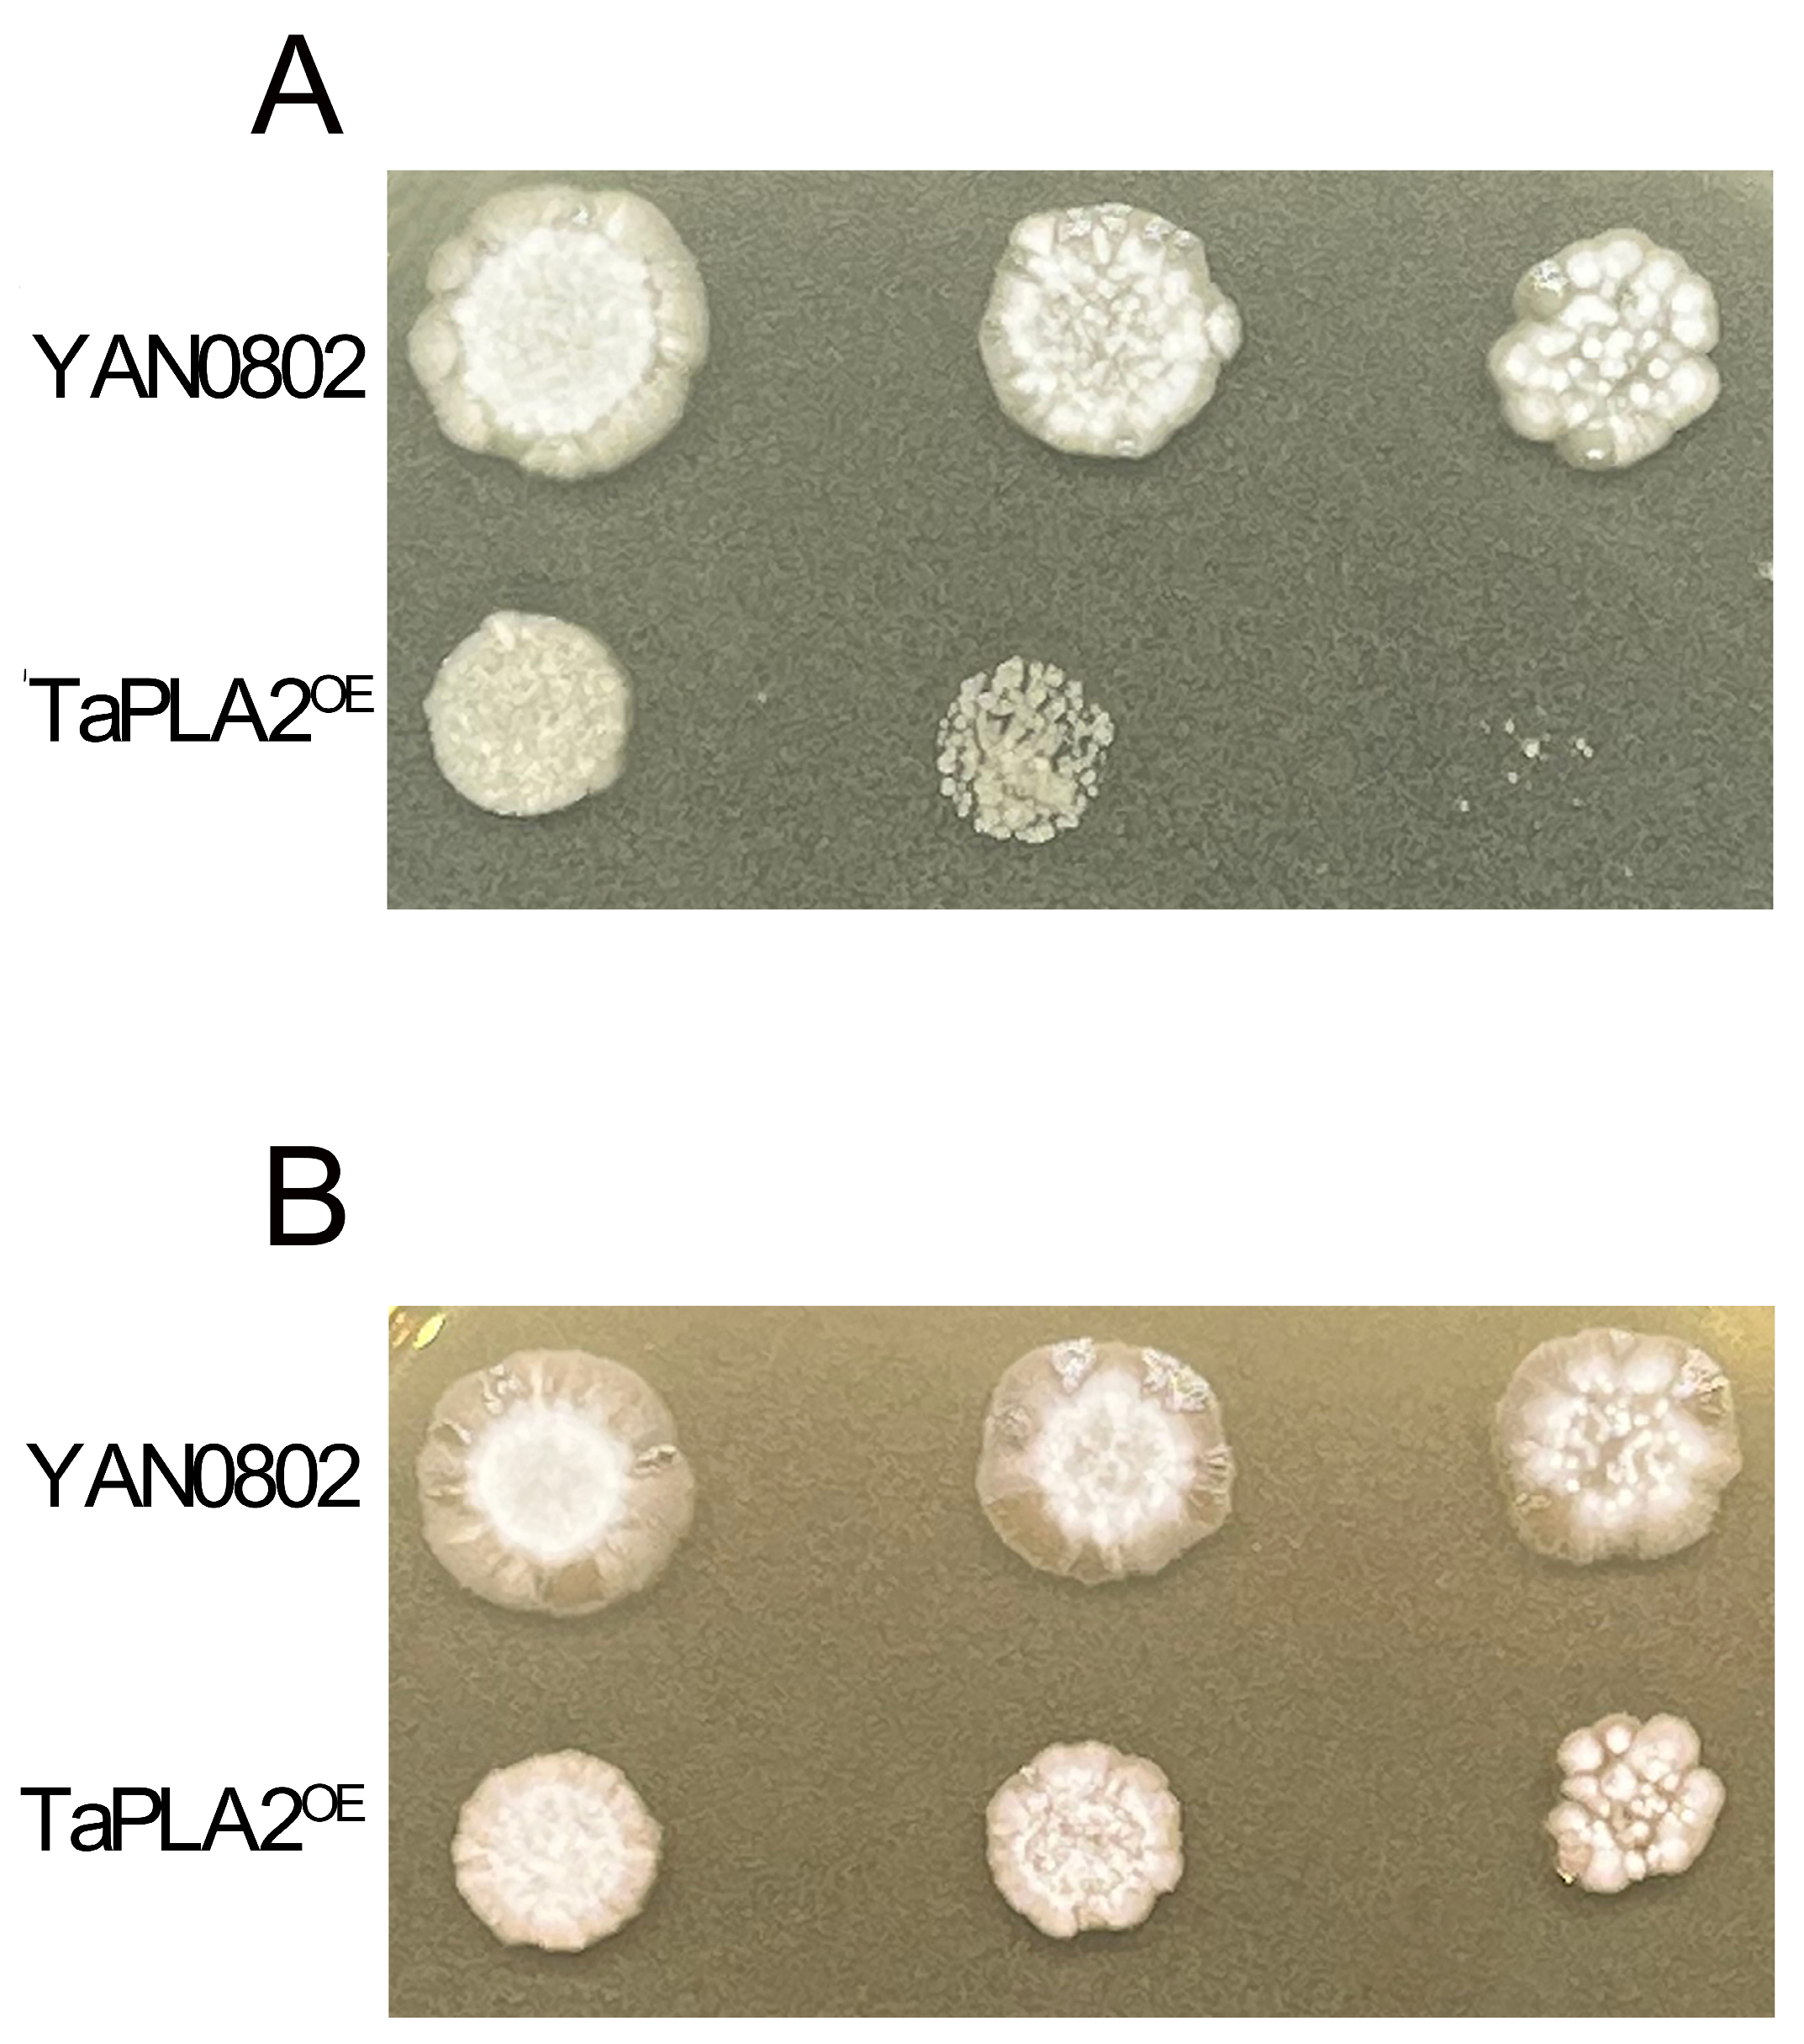
Ijms 24 08855 g008

Trichosporon asahii PLA2 Gene Enhances Drug Resistance to Azoles by Improving Drug Efflux and Biofilm Formation
Abstract
1. Introduction
2. Results
2.1. Identification of PLA2 in T. asahii
2.2. Establishing Overexpressed T. asahii Strain
2.3. TaPLA2 Overexpression Enhanced Phospholipase Activity
2.4. T. asahii Drug Resistance
2.5. Overexpression of TaPLA2 Alters Colony Morphology
2.6. Overexpression of TaPLA2 Enhanced Efflux Ability to Promote Drug Resistance
2.7. Overexpression of TaPLA2 Enhanced Biofilm Formation to Promote Drug Resistance
2.8. TaPLA2 Overexpressed Mutant Impaired Cell Wall Integrity
3. Discussion
4. Materials and Methods
4.1. Strains and Growth Conditions
4.2. Construction of Overexpression Strains
4.3. RT-qPCR
4.4. Phospholipase Activity
4.5. Characterization of OE Mutant Strains
4.6. Drug Sensitivity Test
4.6.1. Antifungal Susceptibility
4.6.2. Biofilm Assay
4.6.3. Detection of Cell Wall Integrity
4.7. Statistical Analysis
5. Conclusions
Supplementary Materials
Author Contributions
Funding
Data Availability Statement
Conflicts of Interest
References
- Marine, M.; Bom, V.L.; de Castro, P.A.; Winkelstroter, L.K.; Ramalho, L.N.; Brown, N.A.; Goldman, G.H. The development of animal infection models and antifungal efficacy assays against clinical isolates of Trichosporon asahii, T. asteroides and T. inkin. Virulence 2015, 6, 476–486. [Google Scholar] [CrossRef] [PubMed]
- Cheng, X.; Zhu, H.; Bai, S.; Zou, Y.; Xia, Z.; Yang, R. Pathogenicity of phospholipase B1 of Trichosporon asahii in immunosuppressed mice. Mycoses 2023, 66, 467–476. [Google Scholar] [CrossRef] [PubMed]
- Krcmery, V., Jr.; Mateicka, F.; Kunova, A.; Spanik, S.; Gyarfas, J.; Sycova, Z.; Trupl, J. Hematogenous trichosporonosis in cancer patients: Report of 12 cases including 5 during prophylaxis with itraconazol. Support. Care Cancer 1999, 7, 39–43. [Google Scholar] [CrossRef]
- Falk, R.; Wolf, D.G.; Shapiro, M.; Polacheck, I. Multidrug-resistant Trichosporon asahii isolates are susceptible to voriconazole. J. Clin. Microbiol. 2003, 41, 911. [Google Scholar] [CrossRef]
- Zavrel, M.; White, T.C. Medically important fungi respond to azole drugs: An update. Future Microbiol. 2015, 10, 1355–1373. [Google Scholar] [CrossRef]
- Kurakado, S.; Miyashita, T.; Chiba, R.; Sato, C.; Matsumoto, Y.; Sugita, T. Role of arthroconidia in biofilm formation by Trichosporon asahii. Mycoses 2020, 64, 42–47. [Google Scholar] [CrossRef] [PubMed]
- Iturrieta-Gonzalez, I.A.; Padovan, A.C.; Bizerra, F.C.; Hahn, R.C.; Colombo, A.L. Multiple species of Trichosporon produce biofilms highly resistant to triazoles and amphotericin B. PLoS ONE 2014, 9, e109553. [Google Scholar] [CrossRef]
- Duarte-Oliveira, C.; Rodrigues, F.; Goncalves, S.M.; Goldman, G.H.; Carvalho, A.; Cunha, C. The Cell Biology of the Trichosporon-Host Interaction. Front. Cell. Infect. Microbiol. 2017, 7, 118. [Google Scholar] [CrossRef]
- Wu, W.; Li, W.; Huang, C.J.B. Phospholipase A2, a nonnegligible enzyme superfamily in gastrointestinal diseases. Biochimie 2022, 194, 79–95. [Google Scholar] [CrossRef]
- Dennis, E.A.; Cao, J.; Hsu, Y.H.; Magrioti, V.; Kokotos, G. Phospholipase A2 enzymes: Physical structure, biological function, disease implication, chemical inhibition, and therapeutic intervention. Chem. Rev. 2011, 111, 6130–6185. [Google Scholar] [CrossRef]
- Ivanušec, A.; Šribar, J.; Križaj, I. Secreted Phospholipases A2—Not just Enzymes: Revisited. Int. J. Biol. Sci. 2022, 18, 873–888. [Google Scholar] [CrossRef] [PubMed]
- Murakami, M.; Taketomi, Y.; Miki, Y.; Sato, H.; Hirabayashi, T.; Yamamoto, K. Recent progress in phospholipase A2 research: From cells to animals to humans. Prog. Lipid Res. 2011, 50, 152–192. [Google Scholar] [CrossRef] [PubMed]
- Murakami, M.; Sato, H.; Taketomi, Y. Updating Phospholipase A2 Biology. Biomolecules 2020, 10, 1457. [Google Scholar] [CrossRef]
- Murakami, M.; Sato, H.; Miki, Y.; Yamamoto, K.; Taketomi, Y. A new era of secreted phospholipase A2. J. Lipid Res. 2015, 56, 1248–1261. [Google Scholar] [CrossRef] [PubMed]
- Brglez, V.; Lambeau, G.; Petan, T. Secreted phospholipases A2 in cancer: Diverse mechanisms of action. Biochimie 2014, 107 Pt A, 114–123. [Google Scholar] [CrossRef]
- Deng, J.; Lu, Z.; Wang, H.; Li, N.; Song, G.; Zhu, Q.; Sun, J.; Zhang, Y. A secretory phospholipase A2 of a fungal pathogen contributes to lipid droplet homeostasis, assimilation of insect-derived lipids, and repression of host immune responses. Insect Sci. 2022, 29, 1685–1702. [Google Scholar] [CrossRef] [PubMed]
- Barman, A.; Tamuli, R. Multiple cellular roles of Neurospora crassa plc-1, splA2, and cpe-1 in regulation of cytosolic free calcium, carotenoid accumulation, stress responses, and acquisition of thermotolerance. J. Microbiol. 2015, 53, 226–235. [Google Scholar] [CrossRef]
- Jamiu, A.T.; Albertyn, J.; Sebolai, O.; Gcilitshana, O.; Pohl, C.H. Inhibitory effect of polyunsaturated fatty acids alone or in combination with fluconazole on Candida krusei biofilms in vitro and in Caenorhabditis elegans. Med. Mycol. 2021, 59, 1225–1237. [Google Scholar] [CrossRef]
- Pal, S.E.; Toth, R.; Nosanchuk, J.D.; Vagvolgyi, C.; Nemeth, T.; Gacser, A. A Candida parapsilosis Overexpression Collection Reveals Genes Required for Pathogenesis. J. Fungi 2021, 7, 97. [Google Scholar] [CrossRef]
- Matsumoto, Y.; Nagamachi, T.; Yoshikawa, A.; Yamazaki, H.; Yamasaki, Y.; Yamada, T.; Sugita, T. Development of an efficient gene-targeting system for elucidating infection mechanisms of the fungal pathogen Trichosporon asahii. Sci. Rep. 2021, 11, 18270. [Google Scholar] [CrossRef]
- Schubert, S.; Barker, K.S.; Znaidi, S.; Schneider, S.; Dierolf, F.; Dunkel, N.; Aid, M.; Boucher, G.; Rogers, P.D.; Raymond, M.; et al. Regulation of efflux pump expression and drug resistance by the transcription factors Mrr1, Upc2, and Cap1 in Candida albicans. Antimicrob. Agents Chemother. 2011, 55, 2212–2223. [Google Scholar] [CrossRef]
- Du, Y.; Xia, Y.; Jin, K. Enhancing the Biocontrol Potential of the Entomopathogenic Fungus in Multiple Respects via the Overexpression of a Transcription Factor Gene MaSom1. J. Fungi 2022, 8, 105. [Google Scholar] [CrossRef] [PubMed]
- Cabral, V.; Znaidi, S.; Walker, L.A.; Martin-Yken, H.; Dague, E.; Legrand, M.; Lee, K.; Chauvel, M.; Firon, A.; Rossignol, T.; et al. Targeted changes of the cell wall proteome influence Candida albicans ability to form single- and multi-strain biofilms. PLoS Pathog. 2014, 10, e1004542. [Google Scholar] [CrossRef] [PubMed]
- Schillig, R.; Morschhauser, J. Analysis of a fungus-specific transcription factor family, the Candida albicans zinc cluster proteins, by artificial activation. Mol. Microbiol. 2013, 89, 1003–1017. [Google Scholar] [CrossRef] [PubMed]
- Schwarzmuller, T.; Ma, B.; Hiller, E.; Istel, F.; Tscherner, M.; Brunke, S.; Ames, L.; Firon, A.; Green, B.; Cabral, V.; et al. Systematic phenotyping of a large-scale Candida glabrata deletion collection reveals novel antifungal tolerance genes. PLoS Pathog. 2014, 10, e1004211. [Google Scholar] [CrossRef] [PubMed]
- Znaidi, S.; van Wijlick, L.; Hernandez-Cervantes, A.; Sertour, N.; Desseyn, J.L.; Vincent, F.; Atanassova, R.; Gouyer, V.; Munro, C.A.; Bachellier-Bassi, S.; et al. Systematic gene overexpression in Candida albicans identifies a regulator of early adaptation to the mammalian gut. Cell. Microbiol. 2018, 20, e12890. [Google Scholar] [CrossRef] [PubMed]
- Nevalainen, T.J.; Cardoso, J.C.R.; Riikonen, P.T. Conserved domains and evolution of secreted phospholipases A2. FEBS J. 2012, 279, 636–649. [Google Scholar] [CrossRef] [PubMed]
- Matsumoto, Y.; Yamazaki, H.; Yamasaki, Y.; Tateyama, Y.; Yamada, T.; Sugita, T. A novel silkworm infection model with fluorescence imaging using transgenic Trichosporon asahii expressing eGFP. Sci. Rep. 2020, 10, 10991. [Google Scholar] [CrossRef]
- Han, X.F.; Li, H.T.; Yang, R.Y.; Zhang, Y.M.; Tian, Y.L.; Zhou, J.F.; Yang, D.Q. The change of morphology and antifungal susceptibility in Trichosporon asahii by in-vivo passage and in-vitro induction. J. Pract. Dermatol. 2015, 8, 6–10. [Google Scholar]
- Song, J.; Zhou, J.; Zhang, L.; Li, R. Mitochondria-Mediated Azole Drug Resistance and Fungal Pathogenicity: Opportunities for Therapeutic Development. Microorganisms 2020, 8, 1574. [Google Scholar] [CrossRef]
- Liu, Y.; Ma, C.; Mao, X.; Zhao, Q.; Yu, D.; Yang, L.; Li, M. Function of the phosphatidylinositol synthase Pis1 in maintenance of endoplasmic reticulum function and pathogenicity in Candida albicans. Fungal Genet. Biol. 2022, 160, 103674. [Google Scholar] [CrossRef]
- Kim, Y.G.; Lee, J.H.; Park, J.G.; Lee, J. Inhibition of Candida albicans and Staphylococcus aureus biofilms by centipede oil and linoleic acid. Biofouling 2020, 36, 126–137. [Google Scholar] [CrossRef] [PubMed]
- Barman, A.; Gohain, D.; Bora, U.; Tamuli, R. Phospholipases play multiple cellular roles including growth, stress tolerance, sexual development, and virulence in fungi. Microbiol. Res. 2018, 209, 55–69. [Google Scholar] [CrossRef] [PubMed]
- Yadav, U.; Khan, M.A. Targeting the GPI biosynthetic pathway. Pathog. Glob. Health 2018, 112, 115–122. [Google Scholar] [CrossRef] [PubMed]
- Jiménez-Gutiérrez, E.; Alegría-Carrasco, E.; Alonso-Rodríguez, E.; Fernández-Acero, T.; Molina, M.; Martín, H.J.T.F. Rewiring the yeast cell wall integrity (CWI) pathway through a synthetic positive feedback circuit unveils a novel role for the MAPKKK Ssk2 in CWI pathway activation. FEBS J. 2020, 287, 4881–4901. [Google Scholar] [CrossRef] [PubMed]
- She, X.D.; Gao, Y.; Zhang, L.L.; Shen, Y.N.; Li, D.M.; Liu, W.D. Effects of Candida albicans mitochondrial dysfunction on cell wall structure and virulence. China J. Lepr. Ski. Dis. 2015, 31, 195–197, 208. [Google Scholar]
- Wen, Y.-Y.; Huang, X.; Sheng, S.; Zhao, J. A Study of fluconzole resistance mechanism of Candida albicans based on Hog-MAPK signal pathway. Chin. J. Mycol. 2015, 10, 345–351. [Google Scholar]
- Pemmaraju, S.C.; Padmapriya, K.; Pruthi, P.A.; Prasad, R.; Pruthi, V. Impact of oxidative and osmotic stresses on Candida albicans biofilm formation. Biofouling 2016, 32, 897–909. [Google Scholar] [CrossRef]
- Siafakas, A.R.; Sorrell, T.C.; Wright, L.C.; Wilson, C.; Larsen, M.; Boadle, R.; Williamson, P.R.; Djordjevic, J.T. Cell wall-linked cryptococcal phospholipase B1 is a source of secreted enzyme and a determinant of cell wall integrity. J. Biol. Chem. 2007, 282, 37508–37514. [Google Scholar] [CrossRef]
- Gao, F.; Zhou, B.J.; Li, G.Y.; Jia, P.S.; Li, H.; Zhao, Y.L.; Zhao, P.; Xia, G.X.; Guo, H.S. A glutamic acid-rich protein identified in Verticillium dahliae from an insertional mutagenesis affects microsclerotial formation and pathogenicity. PLoS ONE 2010, 5, e15319. [Google Scholar] [CrossRef] [PubMed]
- Gokce, G.; Cerikcioglu, N.; Yagci, A. Acid proteinase, phospholipase, and biofilm productionof Candida species isolated from blood cultures. Mycopathologia 2007, 164, 265. [Google Scholar] [CrossRef]
- Zhu, H.; Yang, R.Y.; Ao, J.H.; Wang, W.L. Comparison of the secretory level of extracellular protease from Trichosporon asahiis. J. Pract. Dermatol. 2012, 5, 199–201. [Google Scholar]
- Samaranayake, Y.H.; Dassanayake, R.S.; Jayatilake, J.A.; Cheung, B.P.; Yau, J.Y.; Yeung, K.W.; Samaranayake, L.P. Phospholipase B enzyme expression is not associated with other virulence attributes in Candida albicans isolates from patients with human immunodeficiency virus infection. J. Med. Microbiol. 2005, 54 Pt 6, 583–593. [Google Scholar] [CrossRef] [PubMed]
- Leong, C.; Buttafuoco, A.; Glatz, M.; Bosshard, P.P. Antifungal Susceptibility Testing of Malassezia spp. with an Optimized Colorimetric Broth Microdilution Method. J. Clin. Microbiol. 2017, 55, 1883–1893. [Google Scholar] [CrossRef] [PubMed]
- Leong, C.; Kit, J.C.W.; Lee, S.M.; Lam, Y.I.; Goh, J.P.Z.; Ianiri, G.; Dawson, T.L. Azole Resistance Mechanisms in Pathogenic Malassezia furfur. Antimicrob. Agents Chemother. 2021, 65, e01975-20. [Google Scholar] [CrossRef]
- Ramage, G.; Vande Walle, K.; Wickes, B.L.; Lopez-Ribot, J.L. Standardized method for in vitro antifungal susceptibility testing of Candida albicans biofilms. Antimicrob. Agents Chemother. 2001, 45, 2475–2479. [Google Scholar] [CrossRef]
- Di Bonaventura, G.; Pompilio, A.; Picciani, C.; Iezzi, M.; D’Antonio, D.; Piccolomini, R. Biofilm formation by the emerging fungal pathogen Trichosporon asahii: Development, architecture, and antifungal resistance. Antimicrob. Agents Chemother. 2006, 50, 3269–3276. [Google Scholar] [CrossRef]

| Colony Diameter (mm) | Precipitation Diameter (mm) | Pz (x ± s) | |
|---|---|---|---|
| YAN0802 | 22.83 | 22.83 | 1 |
| TaPLA2OE | 17.35 | 26.34333 | 0.658 ± 0.029 |
| Name | MIC (μg/mL) | |
|---|---|---|
| YAN0802 | TaPLA2OE | |
| 5-FC | ≥4 | ≥32 |
| AMB | ≥32 | ≥32 |
| VRZ | 0.5 | 2 |
| FLC | 2 | ≥32 |
Disclaimer/Publisher’s Note: The statements, opinions and data contained in all publications are solely those of the individual author(s) and contributor(s) and not of MDPI and/or the editor(s). MDPI and/or the editor(s) disclaim responsibility for any injury to people or property resulting from any ideas, methods, instructions or products referred to in the content. |
© 2023 by the authors. Licensee MDPI, Basel, Switzerland. This article is an open access article distributed under the terms and conditions of the Creative Commons Attribution (CC BY) license (https://creativecommons.org/licenses/by/4.0/).
Share and Cite
Ma, X.; Liu, H.; Liu, Z.; Wang, Y.; Zhong, Z.; Peng, G.; Gu, Y. Trichosporon asahii PLA2 Gene Enhances Drug Resistance to Azoles by Improving Drug Efflux and Biofilm Formation. Int. J. Mol. Sci. 2023, 24, 8855. https://doi.org/10.3390/ijms24108855
Ma X, Liu H, Liu Z, Wang Y, Zhong Z, Peng G, Gu Y. Trichosporon asahii PLA2 Gene Enhances Drug Resistance to Azoles by Improving Drug Efflux and Biofilm Formation. International Journal of Molecular Sciences. 2023; 24(10):8855. https://doi.org/10.3390/ijms24108855
Chicago/Turabian StyleMa, Xiaoping, Hong Liu, Zhen Liu, Ya Wang, Zhijun Zhong, Guangneng Peng, and Yu Gu. 2023. "Trichosporon asahii PLA2 Gene Enhances Drug Resistance to Azoles by Improving Drug Efflux and Biofilm Formation" International Journal of Molecular Sciences 24, no. 10: 8855. https://doi.org/10.3390/ijms24108855
APA StyleMa, X., Liu, H., Liu, Z., Wang, Y., Zhong, Z., Peng, G., & Gu, Y. (2023). Trichosporon asahii PLA2 Gene Enhances Drug Resistance to Azoles by Improving Drug Efflux and Biofilm Formation. International Journal of Molecular Sciences, 24(10), 8855. https://doi.org/10.3390/ijms24108855

